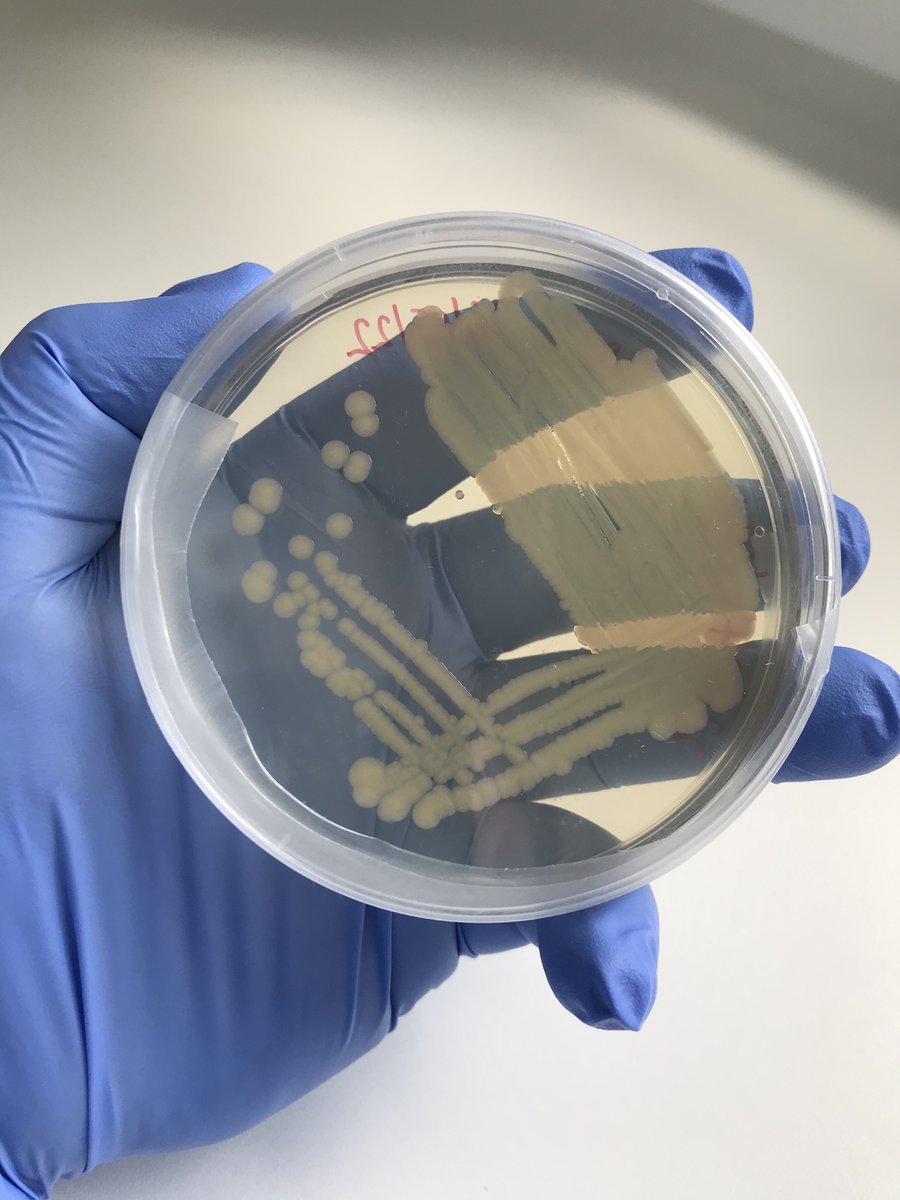
Fish Health, Ageing and Non-Native Species tweet media

Fish Health, Ageing and Non-Native Species
322 posts

Fish Health, Ageing and Non-Native Species
@FishLab_EA
Environment Agency Fish Health, Ageing and Non-Native Species Team
Katılım Şubat 2018
344 Takip Edilen563 Takipçiler

Interested in #Fish and #Fisheries ? Have applied molecular #science knowledge and experience to answer ecological questions? Looking for a new role? Consider one of our vacancies below @EnvAgency @EnvAgencyAnglia #fishsci
English

We recently visited the team at Calverton @FishFarmEA to understand what it takes to produce high quality, healthy #fish to benefit #rivers and #fisheries nationwide. It was a fantastic tour to see and understand each stage of their fish production facility. #TeamEA



English
Fish Health, Ageing and Non-Native Species retweetledi

Topmouth gudgeon is a highly invasive non-native fish species and pose a significant threat to native biodiversity in our lakes and rivers. They can outcompete native species for food and resources. #INNSWeek @InvasiveSp

English

#INNS can be spread in many ways, with some being introduced deliberately, others accidentally with other species. At the @EnvAgency Fisheries Laboratory we have detected a number of invasive pathogens and work with fishery owners to protect the environment #INNSweek @InvasiveSp


English

Did you know that here at the @EnvAgency National Fisheries Laboratory we detect and monitor a number of #nonnative #fish #diseases and #parasites.
Check out the following video below to find out more about invasive non-native species. #INNSweek #InvasiveSpeciesWeek
Invasive Species Week@InvasiveSp
It’s #INNSweek 2023! Organisations across the #UK #Ireland #Guernsey #Jersey and #IsleOfMan are working together to raise awareness of: - invasive non-native species🦞🌱🦝 - their impacts - how you can help Watch our video then order a free INNS guide 👇 nonnativespecies.org/invasivespecie…
English
Fish Health, Ageing and Non-Native Species retweetledi

Our #fisheries team have been at a fishery near #Worcester where we have caught a sample of perch, roach & bream for a health check at @FishLab_EA
This type of fisheries management is all funded by the rod licence.
Make sure you have your licence👇
gov.uk/fishing-licenc…



English

Have you ever wondered how to age a fish and what we can learn from fish scales, check out this blog from our very own Conor McCormick
environmentagency.blog.gov.uk/2023/04/21/the…
#fishsci #fish @EnvAgency @GarethDDaviesEA
English

We are hiring - all permanent positions! Please get in touch if interested, deadline is 22nd February #fishsci @EnvAgencyAnglia @EnvAgency environmentagencyjobs.tal.net/vx/lang-en-GB/…
English

This weekend we hosted @IFMFish2 for the IFM Diploma course and showcased what we do in the lab, as well as a fish dissection! A wonderful weekend sharing and learning about fish health with keen fish enthusiasts! #FishHealth

English
Fish Health, Ageing and Non-Native Species retweetledi
Fish Health, Ageing and Non-Native Species retweetledi

Another excellent practical demonstration from @FishLab_EA , our gracious hosts for the day as part of our IFM Diploma course practical weekend.

English
Fish Health, Ageing and Non-Native Species retweetledi

Yesterday @EnvAgencyMids #FisheriesOfficers provided support to #Gloucester #AnglingClub
A sample of fish were removed to be health checked at @FishLab_EA
Hopefully we will receive a clean bill of health so we can safely move the fish to a new pool.
Supported by the #RodLicence




English

Now the diagnostic work begins to figure out what #bacterial #species it is! We start by classifying it through biochemical/phenotypical tests to indicate the characteristics of the #bacteria we've cultured. These include Gram staining and catalase, oxidase and motility tests🦠🐟



English

Here is some good #bacterial growth on a sub-culture agar plate from last week. Sub-culturing the original sample plates allows us to separate out individual #strains of #bacteria so that we get pure single-species #colonies of each bacteria from the original sample plate #TeamEA
English




